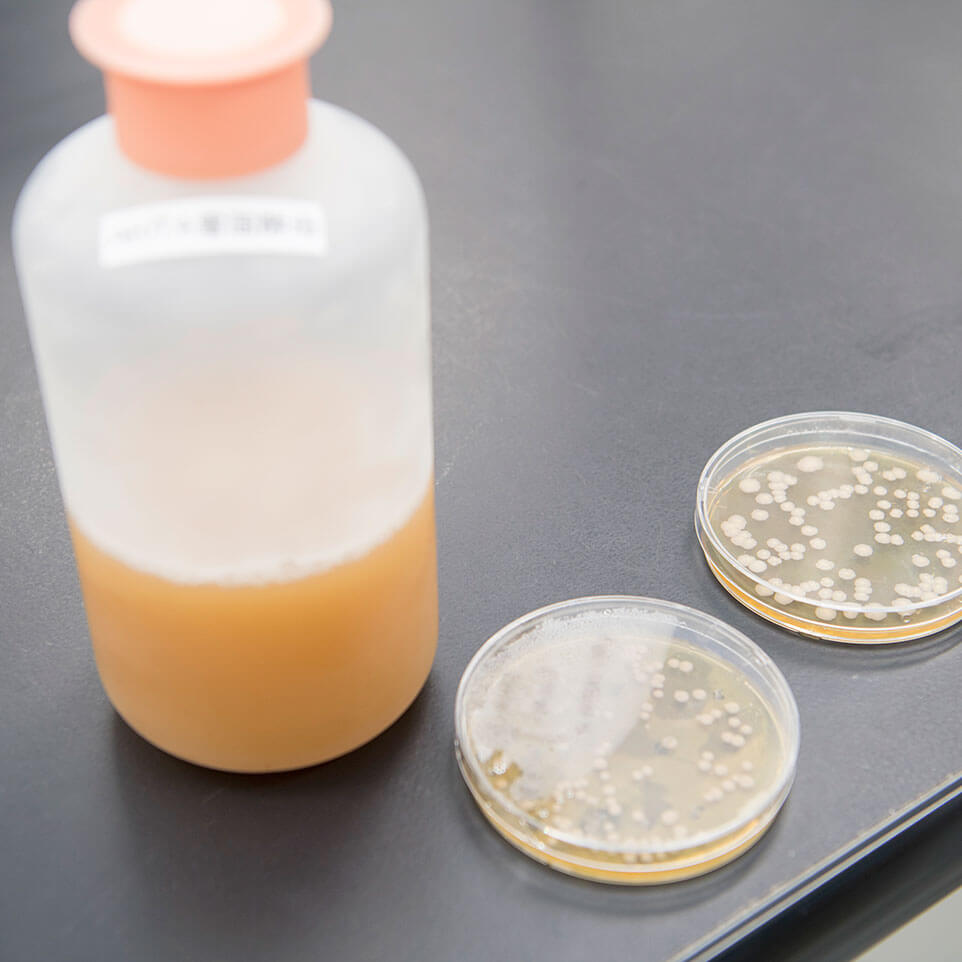
AKITA雪国酵母

秋田県内では、日本酒の価値を高めるための試みが盛んだ。例えば、秋田県酒造組合が行う東京・大阪でのきき酒イベント、新鋭の醸造グループ「NEXT5」のコラボレーション活動、好成績を収めた全国新酒鑑評会やIWC(International Wine Challenge)など、その注目度はとても大きい。
秋田県はこれらをバックアップする取り組みとして、「新しい酵母の開発」を行っている。数多くの純米酒・吟醸酒用酵母を創出している秋田県総合食品研究センターは、新たに「AKITA雪国酵母」「秋田蔵付分離酵母」の開発に成功した。

秋田県総合食品研究センターで微生物の研究を行っている主席研究員の渡邉さんは、日本酒を飲むだけで使っている酵母の種類がわかるという酵母のエキスパート。
秋田県総合食品研究センターが海外向けの日本酒の酵母研究を行うことなったきっかけは、近年の和食ブームだ。年々海外でも和食の人気が高まり、日本から飲食品の輸出量が増えている。日本酒の産地として有名な秋田県は、全国第5位の日本酒生産量を誇る。
だが、秋田県内で生産された日本酒のうち、海外に輸出されるのはわずか1%程度にすぎない。
「日本酒は、酵母の種類によって香りや味が全然違うんです」と酵母の魅力を語る。

秋田県の日本酒輸出量が少ない原因はいくつかある。秋田県に限らず一般的に日本酒を輸出するための大きな障壁となるのが「変化しやすい酒質」だ。
日本酒特有のフルーティな香りは、主にバナナ様と、リンゴ・メロン様の2種類があるが、時間の経過、光、熱、酸素などの影響で変化し、過度に熟成が進むと老香(ひねか)や脂肪酸臭などのオフフレーバーが発生してしまうのだ。
海外では、流通時に低温で荷物を搬送できる条件が整備されていない地域も少なくない。純米大吟醸などの最高峰の日本酒を輸出しても、輸送や店頭環境などの影響で劣化し、消費者に届いたときはオフフレーバーに変化した日本酒になってしまうケースもある。

渡邉さんは「海外へ輸出拡大するためには、温度や光などの環境に左右されず、香りとおいしさを保つことができる日本酒造りが必要だと考えました。そのためには新たな酵母を探す必要があったのです」とプロジェクトの発端を語る。
その結果、誕生したのが「AKITA雪国酵母」だ。
秋田県総合食品研究センターは、「秋田県醸造試験場」を前身とし、1995年に誕生した秋田県立の研究機関。秋田県内の食品産業を支援するため「売れる商品作りの開発支援」「秋田らしい新技術の開発」を行っている。

研究員たちは、10年間の長期計画に基づき、3~5年間でひとつのプロジェクトを遂行する。プロジェクトは企画立案の段階で、センター内や外部機関による審査を行い、実施計画の実現性や研究成果の見込みがある計画のみが研究対象となる。
プロジェクトの具体的な内容は業界のニーズに対応した研究を行なっているが、研究の途中や完了後までセンター内外による評価が行われるだけでなく、一定の研究成果を出すことが求められるという厳しい一面もある研究機関だ。

約3年の歳月を経て誕生した「AKITA雪国酵母」の発見と開発に大きく貢献したのが研究員の上原智美さんだ。
酵母開発は、一般的に数多くの候補株から優良なものを育種・選抜していく。酵母にとって生育が厳しい環境に晒し、生き残った優良な性質を持った酵母を選び、小ロットでの醸造試験を行う。その中で、さらに良い酵母を絞り込む。これを幾度も繰り返す。
上原さんは「酵母選抜の過程で厳しい環境に晒し過ぎてしまい酵母がまったく生育せずに醸造試験をやり直したことが何回かありました」と当時の様子を振り返る。

酵母の選抜が進み、勤務3年目に初めてひとりで15株ほどの酵母をつかって、それぞれ日本酒を造ってみた。しかし、酵母には問題はなかったが、実験的にうまくいかず明らかに日本酒といえない失敗作だった。
「でも、その失敗作の中に味のクリアなものがあったんです」と上原さん。
吟醸酒独特のリンゴとメロン様の香りが強くフレッシュな味わい。この極上のおいしさを生み出した酵母は上原さんのイニシャルを取り「UT-1」と名付けられ、その後、AKITA雪国酵母という名で商品化された。現在、秋田県内の14の蔵元でAKITA雪国酵母を使った日本酒が製造されている。

秋田県は、今後の海外市場とインバウンドの拡大に向け、国内外でAKITA雪国酵母のプロモーション活動も精力的に展開を広げている。